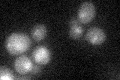
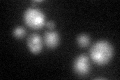

View description
Zn2-Cys6 zinc-finger transcription factor that activates genes involved in multidrug resistance; paralog of Yrm1p, acting on an overlapping set of target genes
Localization:
Intensity:
Fold change:
Significance:
-
C’ GFP library in SD
nucleus19.76 -
N' NOP1pr-GFP in SD

nucleus71.3753 -
N' TEF2pr-mCherry in SD

nucleus70.4642 -
N' NATIVEpr-GFP in SD

below threshold18.9177 -
N' TEF2pr-VC and Cyto-VN in SD

nucleus32.542 -
C’ GFP library in SD+DTT
nucleusN/AN/ANo -
C’ GFP library in SD+H2O2

technical problem0N/ANo -
C’ GFP library in Starvation Media

nucleusN/AN/AYes -
C’ GFP library on the background of Pup2-DaMP

nucleus -
C’ GFP library on the background of CCT mutant

nucleusN/AN/ANo
